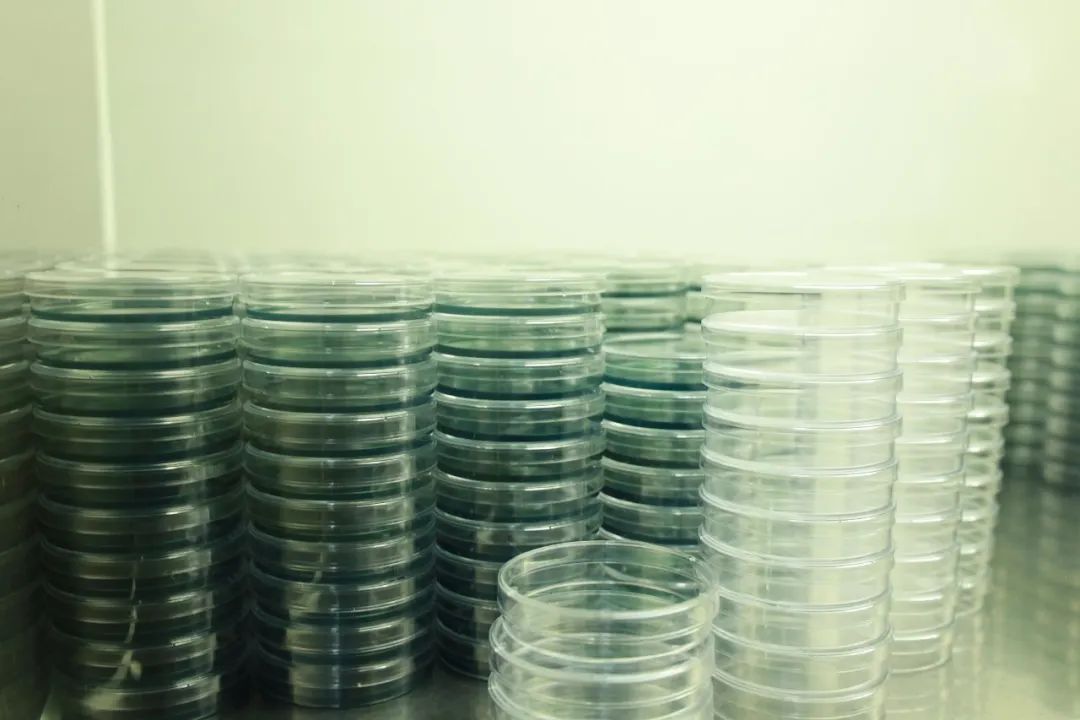

都说大部分人是社会群居动物,我也不例外。这点在我身上表现得最明显的是:我受周围环境影响较大。
说来很庆幸,利洋是我选择以及被选择的第一家公司,用现在流行的话说就是“双向奔赴”。在决定投简历、来面试之前,我做了很多功课。“专业”、“专注”以及“富有人文关怀”是我对利洋整体的印象。长期专注研究且追求极致是“工匠精神”的一种体现,而“利洋”是水产行业中难得的匠人,亦是心怀人民的专家,一心用一身的知识本领竭诚服务基层老百姓。这是利洋对外的人文关怀之体现。

对内亦是如此。我一向摒弃“官僚主义”作风,始终唾弃“头上没官帽却耍官威”的现象,这两者都和强迫别人一层层剥开吃千层蛋糕一样别扭。诚然,对前辈的谦逊、有礼是应有的基本礼节。在利洋,以我所在的研究室为例:平日里,我们都称呼前辈为“X老师”、“X哥”、“X姐”、“师兄”或“师姐”等(X为姓氏或名中的其中一个字),一下模糊掉了彼此来自工龄、职称等的界限。
在利洋,没有人会对你吃千层蛋糕的方式指指点点,大家都能够有自己的发展空间以及试错机会,选择认为最适合自己的岗位,认认真真做好。即便是最后选择离开利洋、另谋他处,利洋也是持尊重、祝福、两不相欠的平和态度。这便是利洋对内的人文关怀。
不论是对内还是对外的人文关怀,利洋始终在努力营造一种让人舒心又不失良好秩序的温暖环境,这或许是利洋独特的企业文化吧。
再说说学习环境。我一向好奇,总是有种想弄明白周遭一切的冲动。所以在实习期间,在我所在的细菌组没有什么要忙的前提下,我会偷偷跑到其他组中,在不打扰对方工作的情况下,看看对方在做什么、不时提问,征得同意后也会帮一下忙。好在,他们并不嫌我烦,似乎还挺乐意我来帮忙,对我的问题也乐于分享自己的见解或是告知我这之中确切的原理。有次陈师姐在给新人打印实验步骤的时候,也给我捎了一份,收到之后真的很开心。

实习了一个多月,我大致摸清了实验操作和基本原理,但各组中核心的学问我仍未把握得很好,比如如何用肉眼初判某单菌落属于哪类致病菌、如何提高鉴定结果的准确度、如何看片等等,我都是处于一知半解的阶段。而且,我还没亲自去了解过细胞组,还未曾摸清细胞室内的“套路”。提笔至此,不由得感慨我在利洋还有好多要学习的地方……还有解剖,我也还是未得精髓!
总而言之,很高兴我得以与利洋相遇!“正信专,共创美好生活”是利洋的企业文化,愿服务人民的利洋人以微火暖万家。尘雾虽微亦可补益山海,荧烛末光尚能增辉日月,希望利洋终得所愿、扬帆起航且能继续稳定砥砺前行!
